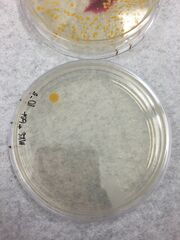
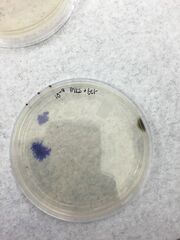

Uploads by Sarah Jo Sleiman
From OpenWetWare
Jump to navigationJump to search
This special page shows all uploaded files.
| Date | Name | Thumbnail | Size | Description |
|---|---|---|---|---|
| 05:29, 11 February 2016 | Table1table1.jpg (file) |  |
1.02 MB | |
| 19:25, 6 February 2016 | 103n.JPG (file) |  |
1.29 MB | |
| 19:24, 6 February 2016 | 103p.JPG (file) |  |
1.52 MB | |
| 19:21, 6 February 2016 | 105p.JPG (file) |  |
1.49 MB | |
| 19:20, 6 February 2016 | 105n.JPG (file) |  |
1.19 MB | |
| 19:15, 6 February 2016 | 3tet-.JPG (file) |  |
101 KB | |
| 19:14, 6 February 2016 | 3tet+.JPG (file) |  |
120 KB | |
| 19:14, 6 February 2016 | 5tet-.JPG (file) |  |
115 KB | |
| 19:13, 6 February 2016 | 5tet+.JPG (file) |  |
133 KB | |
| 19:10, 6 February 2016 | Tabledes2.jpg (file) |  |
829 KB | |
| 19:06, 6 February 2016 | Pl8.JPG (file) |  |
1.52 MB | |
| 19:02, 6 February 2016 | Pl7.JPG (file) |  |
2.56 MB | |
| 19:01, 6 February 2016 | Pl6.JPG (file) |  |
2.31 MB | |
| 18:59, 6 February 2016 | Pl5.JPG (file) |  |
1.79 MB | |
| 18:58, 6 February 2016 | Pl4.JPG (file) |  |
1.7 MB | |
| 18:55, 6 February 2016 | Pl3.JPG (file) |  |
1.85 MB | |
| 18:54, 6 February 2016 | Pl2.JPG (file) | |
1.93 MB | |
| 18:53, 6 February 2016 | Pl1.JPG (file) | |
2.03 MB | |
| 06:02, 29 January 2016 | COLP.jpg (file) |  |
198 KB | |
| 06:01, 29 January 2016 | OV.jpg (file) |  |
1.53 MB | |
| 06:00, 29 January 2016 | COLP.JPG (file) |  |
198 KB | |
| 05:59, 29 January 2016 | OV.JPG (file) |  |
1.53 MB | |
| 05:58, 29 January 2016 | Recording.jpg (file) |  |
809 KB | |
| 06:15, 22 January 2016 | Volvocine Line 1.jpg (file) |  |
1.72 MB | |
| 06:14, 22 January 2016 | Transect Site 2.jpg (file) | 17.93 MB | ||
| 06:13, 22 January 2016 | Volvocine Line 1.JPG (file) |  |
1.72 MB | |
| 06:11, 22 January 2016 | Transect Site 2.JPG (file) | 17.93 MB | ||
| 06:10, 22 January 2016 | Transect Site 1.JPG (file) | 22.19 MB | ||
| 06:08, 22 January 2016 | Aerial Drawing.jpg (file) |  |
1.71 MB | |
| 06:04, 22 January 2016 | Aerial Drawing.JPG (file) |  |
1.71 MB |